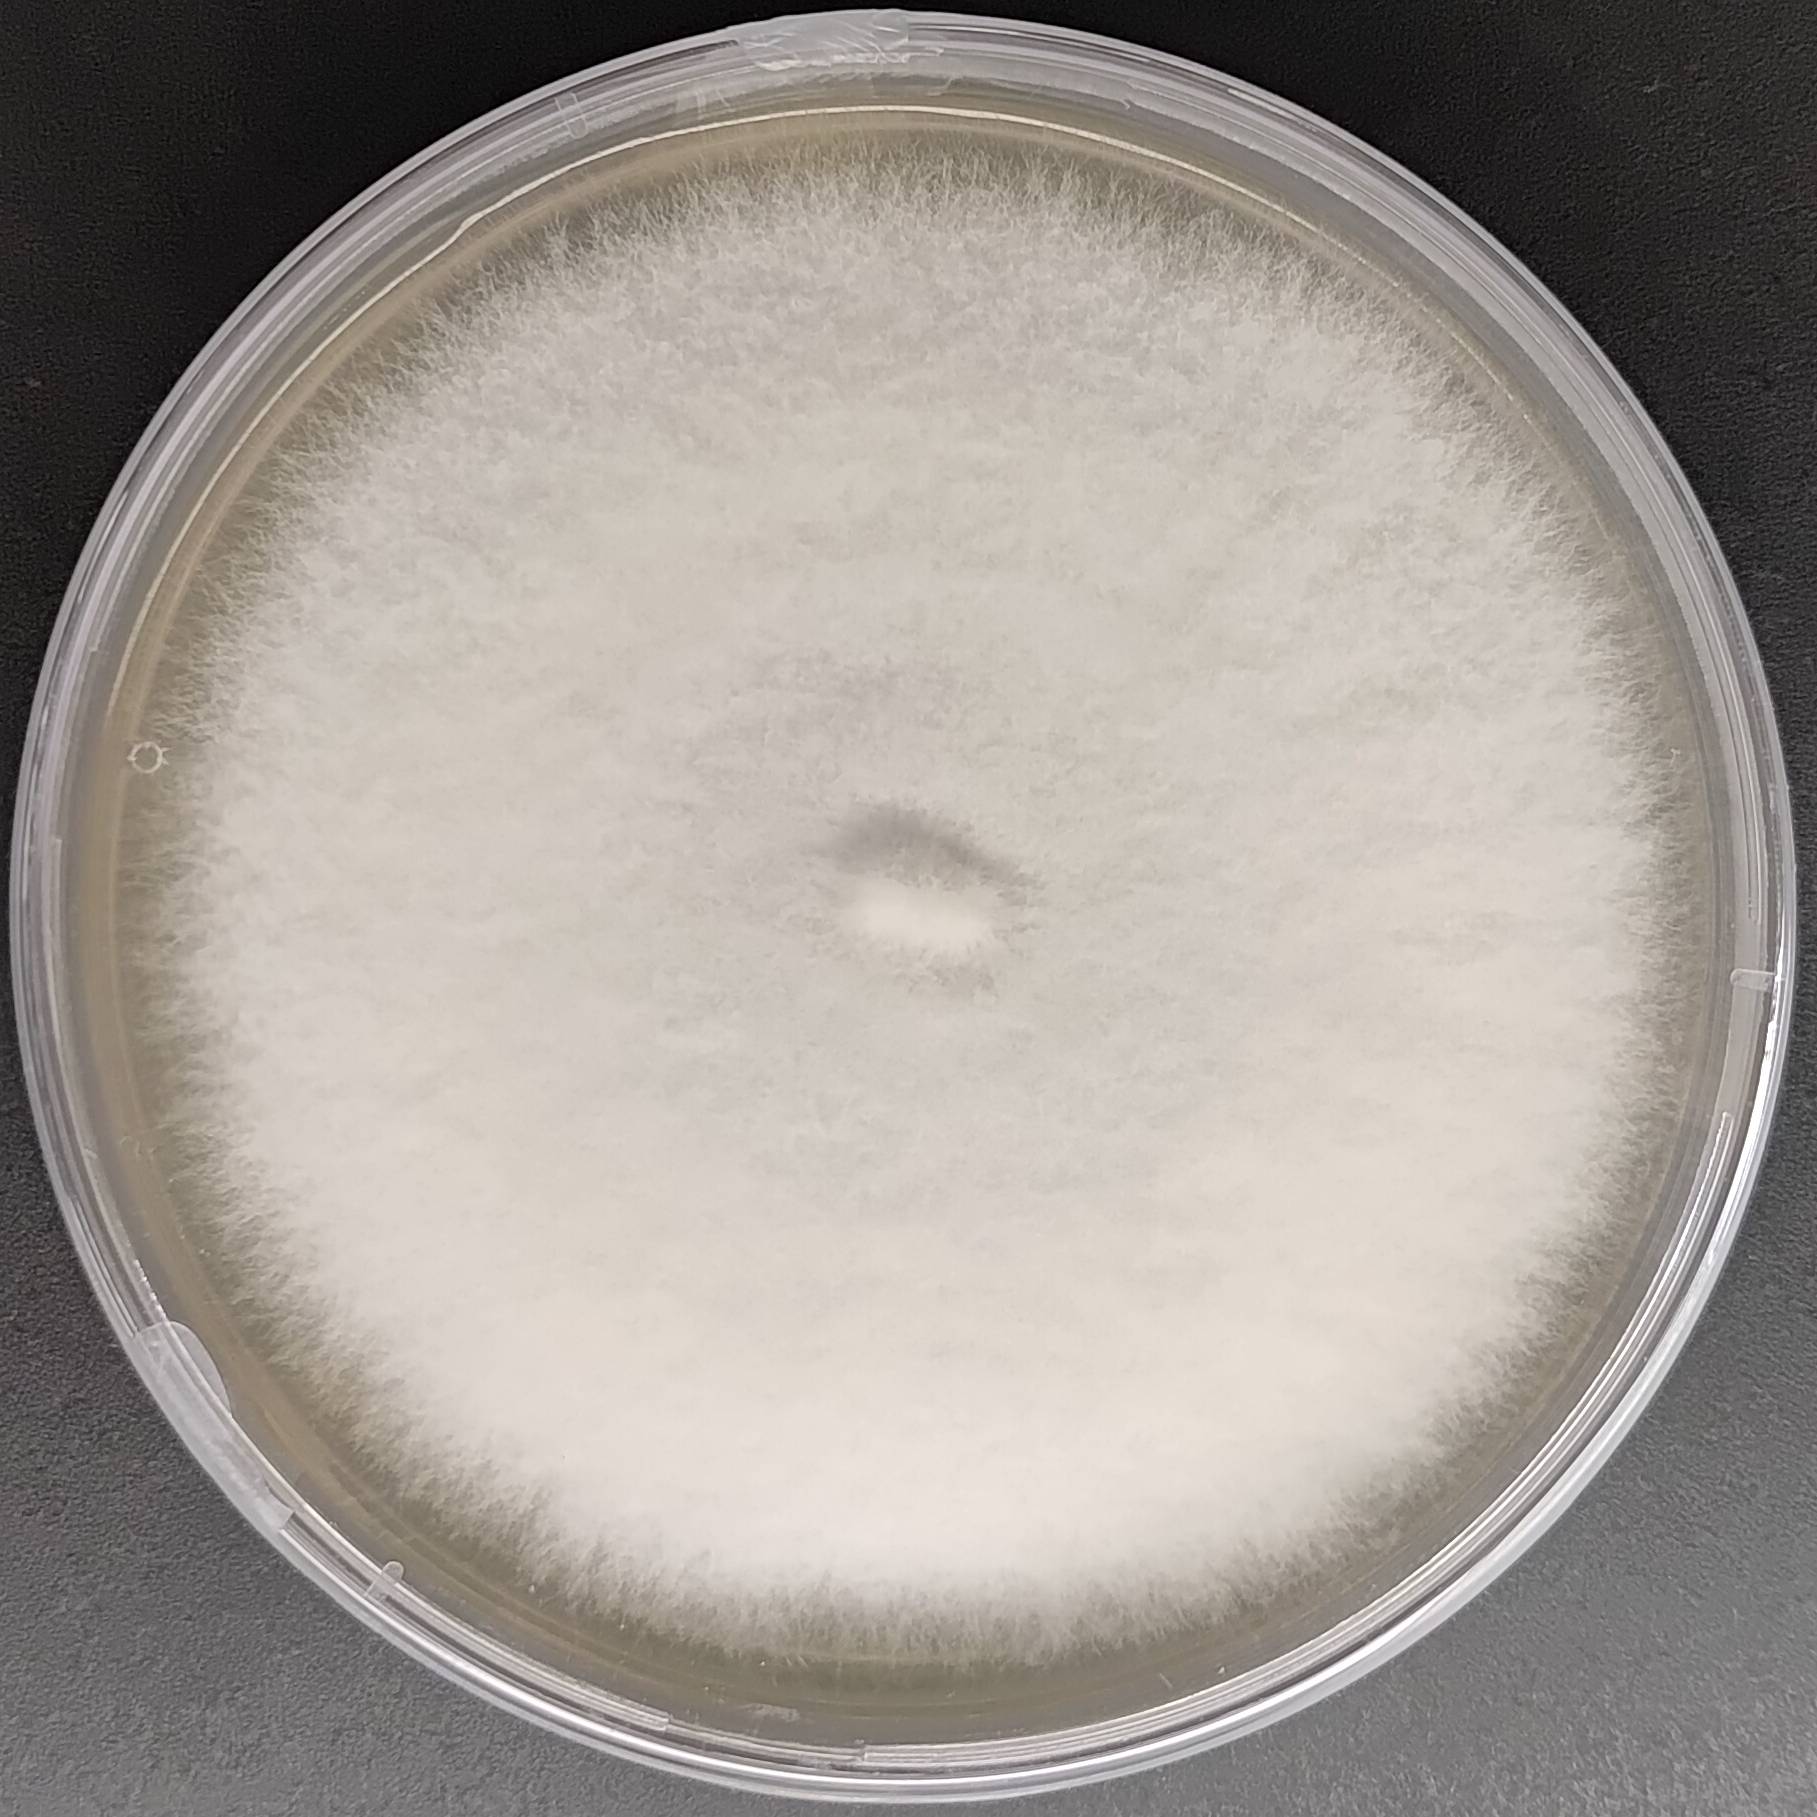
Trametes versicolor Turkey tail Pure Culture
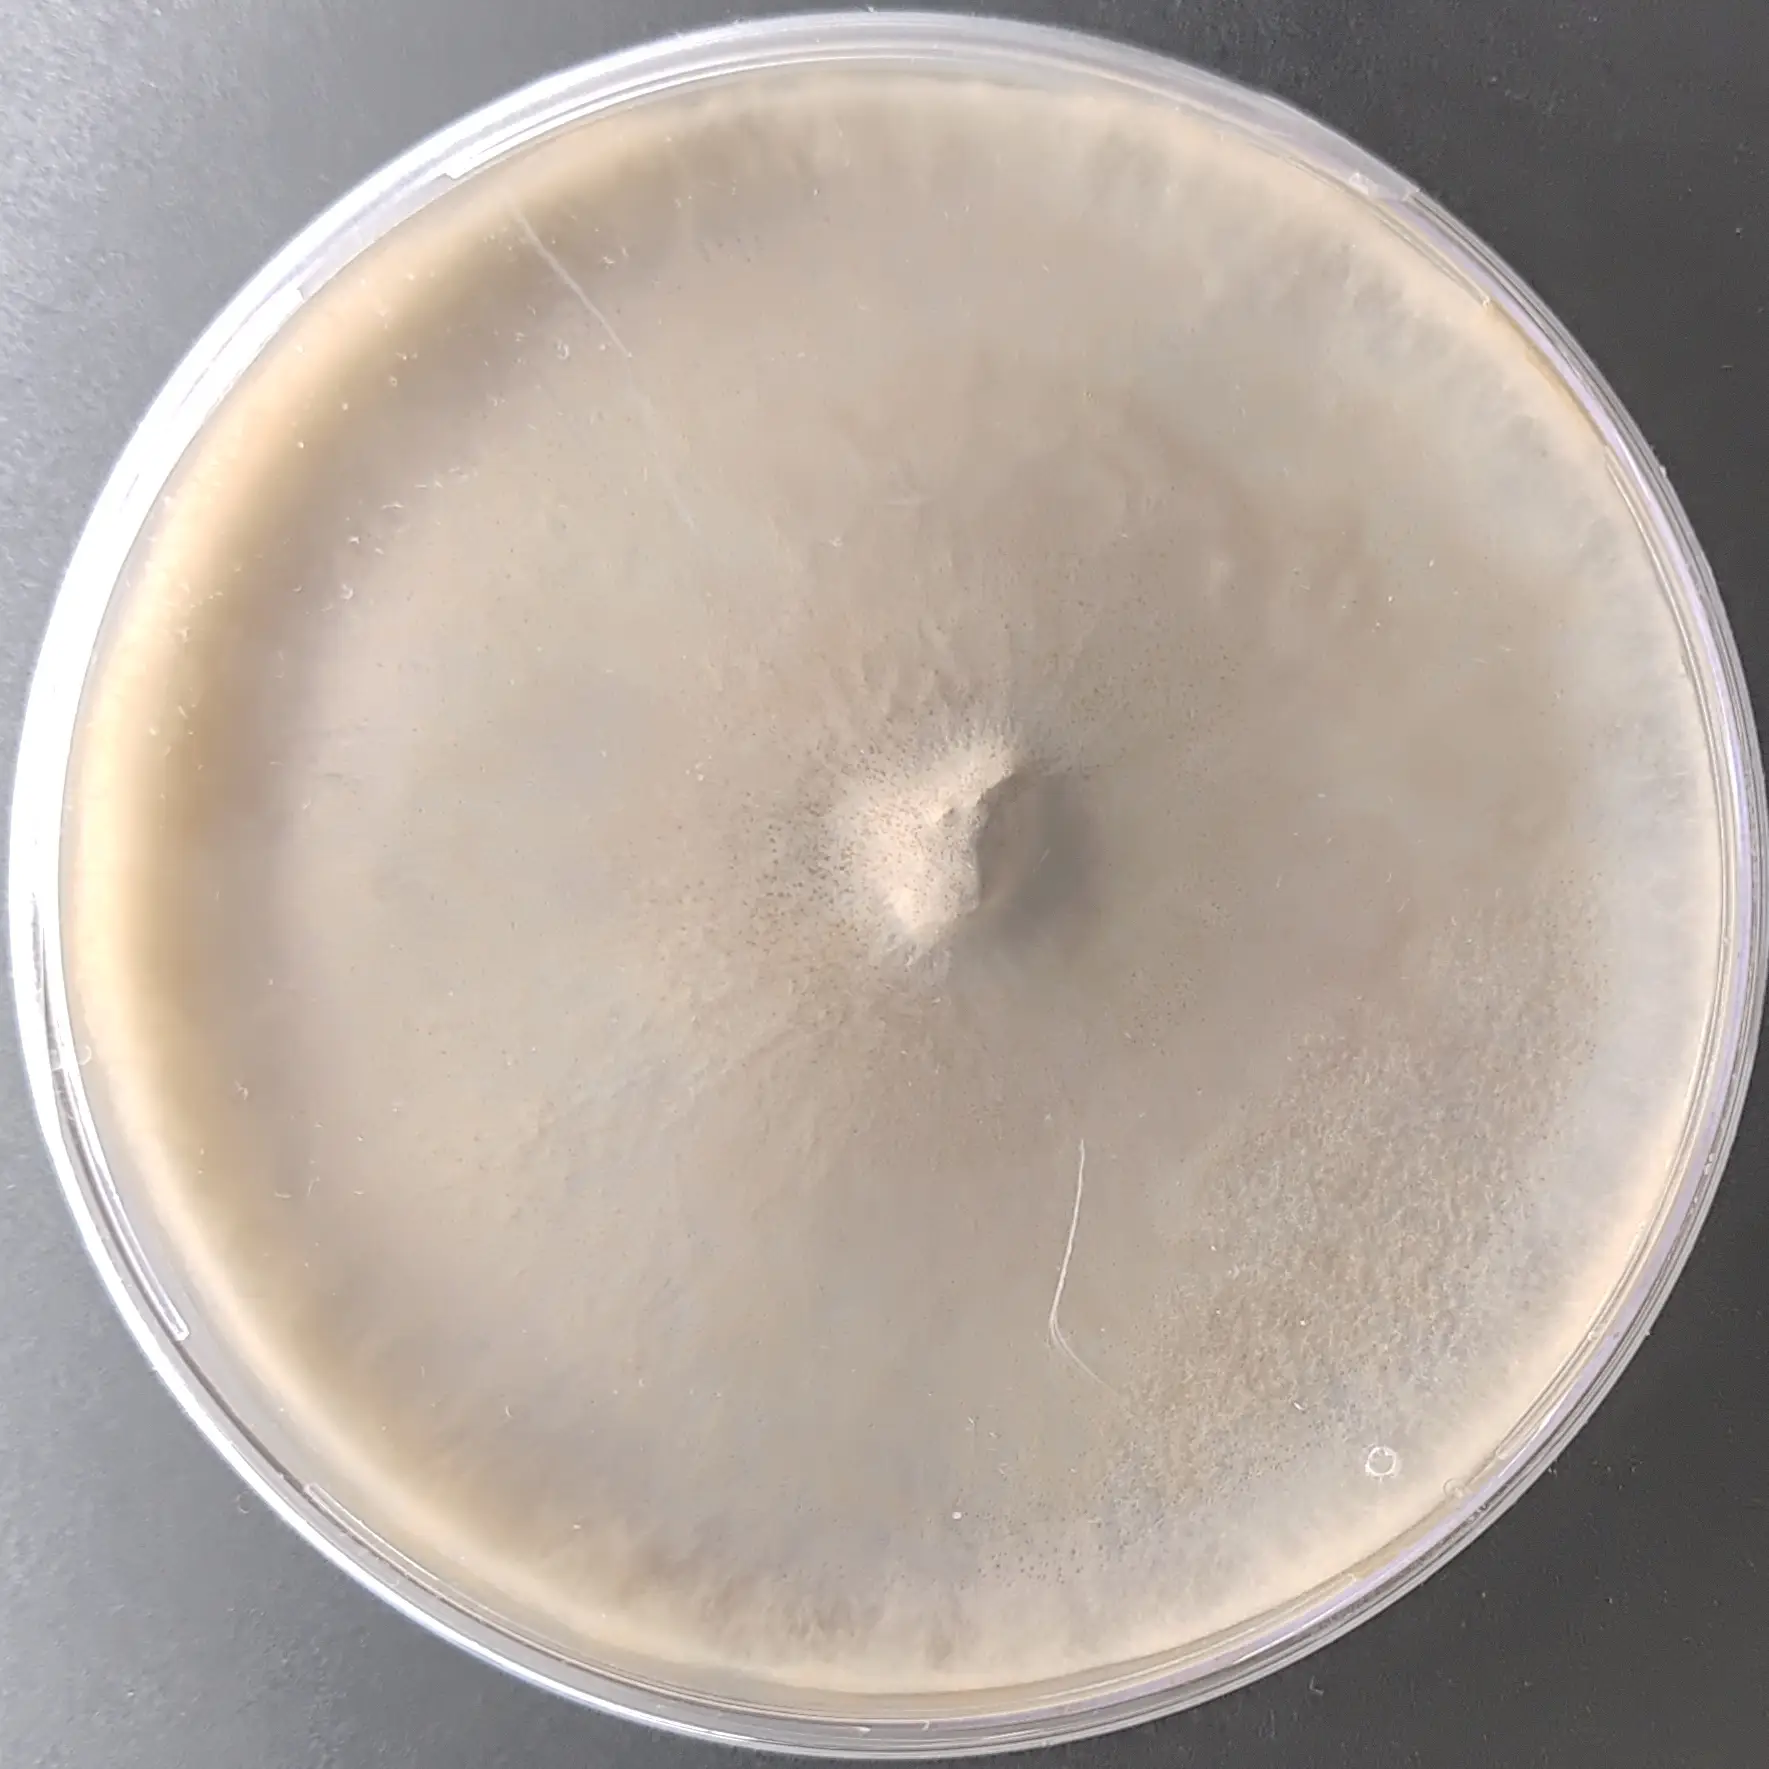
F74 Auricularia polytricha 20251223.webp

Tolypocladium ophioglossoides Goldenthread Cordyceps agar plate
Trametes versicolor Turkey tail Pure Culture
MUHSROOM CULTURE BANK PURE CULTURE - MEDICINAL MUSHROOMS PURE CULTURE - SPECIALTY MUSHROOMS All Products
Tremella fuciformis Snow Fungus Culture
MUHSROOM CULTURE BANK PURE CULTURE - MEDICINAL MUSHROOMS PURE CULTURE - SPECIALTY MUSHROOMS All Products